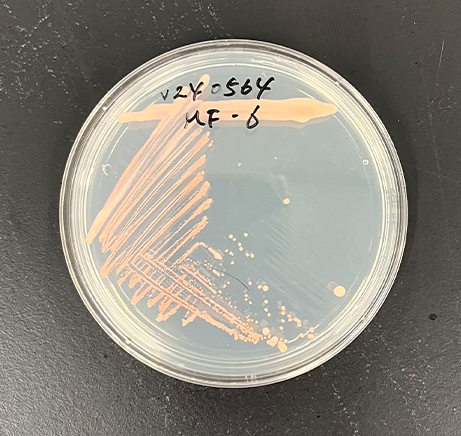

画線方法(バイオバーデンの分離)
微生物を同定するには画線培養によって単離されたコロニーが必要です。
複数の菌が混在しているコロニーでは同定結果が得られません。
画線培養が必要な例

左に示す写真の①~③は単一のコロニーに見えますが、複数の菌が混在している可能性があり、画線培養が必要となります。
自社で画線培養できる設備がない場合は、弊社で実施することも可能です(別途費用)。
なお、画線培養してもコロニーが生育しない場合があります。その場合でも費用は申し受けますので、あらかじめご了承ください。
画線方法
1.白金耳をバーナーの炎などで火炎滅菌し、数秒待って白金耳を冷まします(熱いままだと菌が死ぬためです)。
2.火炎滅菌した白金耳で培養液やコロニーから少量の菌を釣菌し、シャーレのフタを少しだけ開けて①の向きに植菌します。
3.白金耳を再び火炎滅菌して冷まし、①の画線の端に1,2回触れてから②の向きに植菌します。
4.③~⑤についても同様に植菌します。
5.シャーレのフタを閉じ、培地を逆さま(フタを下)にして培養します。培養温度は25℃程度が望ましいです。

画線培養の適切な例
・単一の菌種である(単離できている)
・2.0mm以上のコロニーが複数ある(複数回の同定が可能)


画線培養の不適切な例
・複数の菌種が混ざっている
・2.0mm以上のコロニーがない


試料をお送りいただく前に
培養シャーレには試料名を記入してください。
また、菌種によっては、培養時間が結果に影響を与える場合があります。培養後の試料は室温(25℃)で保存してください。
冷蔵保存しますと、良好な結果が得られなくなる恐れがありますのでご注意ください。